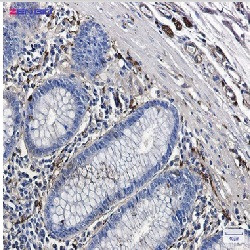
TUBB3 Antibody in Immunohistochemistry (Paraffin) (IHC (P))

Search
Abnova
TUBB3 Recombinant Rabbit Monoclonal Antibody
{{$productOrderCtrl.translations['antibody.pdp.commerceCard.promotion.promotions']}}
{{$productOrderCtrl.translations['antibody.pdp.commerceCard.promotion.viewpromo']}}
{{$productOrderCtrl.translations['antibody.pdp.commerceCard.promotion.promocode']}}: {{promo.promoCode}} {{promo.promoTitle}} {{promo.promoDescription}}. {{$productOrderCtrl.translations['antibody.pdp.commerceCard.promotion.learnmore']}}
产品信息
RAB01558
种属反应
宿主/亚型
Expression System
分类
类型
抗原
偶联物
形式
纯化类型
保存液
内含物
保存条件
运输条件
靶标信息
The betaIII-tubulin isoform is present dominantly in cells of neuronal origin and it is one of the earliest markers of neuronal differentiation. It is regarded as a specific probe for the cells of neuronal origin as well as for the tumours originating from these cells. The betaIII-tubulin is most abundant in cells of neuronal origin, but was also detected in Sertoli cells of the testis and transiently in non-neuronal embryonic tissues.
仅用于科研。不用于诊断过程。未经明确授权不得转售。
篇参考文献 (0)
生物信息学
蛋白别名: beta 3 tubulin; beta tubulin 3; class III beta-tubulin; MC1R; microtubule protein; Neuron specific beta III Tubulin; TUBB; tubulin beta; Tubulin beta-3; Tubulin beta-3 chain; Tubulin beta-4; Tubulin beta-4 chain; Tubulin beta-III; tubulin, beta 3; unnamed protein product
基因别名: beta-4; CDCBM; CDCBM1; CFEOM3; CFEOM3A; FEOM3; TUBB3; TUBB4
UniProt ID: (Human) Q13509
Entrez Gene ID: (Human) 10381